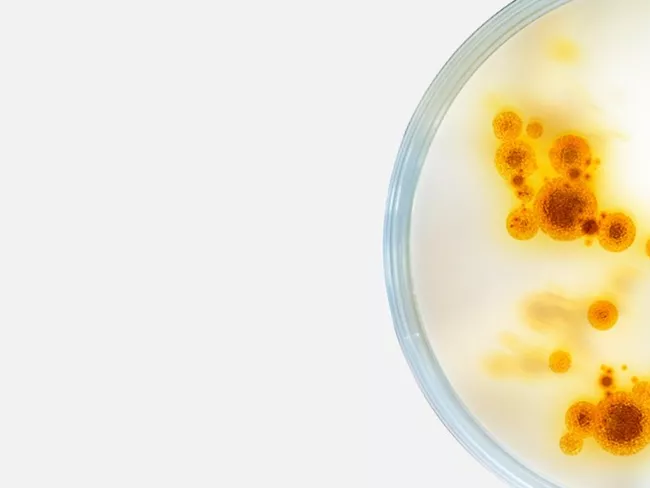

Parcourir les articles

Nous croyons que les déchets d’emballage sont un matériau secondaire – le développement d'infrastructures de collecte, de tri et de recyclage est nécessaire pour faire de cela une réalité
Nous croyons que l'accès à une nourriture saine est un droit universel et nous savons que l'emballage joue un rôle essentiel en faisant en sorte que cela soit possible, dans le monde entier

Nous croyons que la valeur de l'emballage est supérieure à son impact sur la planète

Nous croyons qu'il faut protéger la nourriture grâce à un emballage intelligent tout au long de la chaîne d'approvisionnement
Démystifier les mythes sur l’emballage
- open_in_new La porcelaine battrait le carton
- open_in_new Le prix de la nourriture n'a rien à voir avec son emballage
- open_in_new L'emballage serait juste une autre forme de déchets
